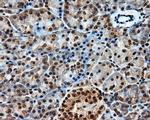
PTPRE Antibody in Immunohistochemistry (Paraffin) (IHC (P))

Search
OriGene
PTPRE Monoclonal Antibody (OTI4B2), TrueMAB™
{{$productOrderCtrl.translations['antibody.pdp.commerceCard.promotion.promotions']}}
{{$productOrderCtrl.translations['antibody.pdp.commerceCard.promotion.viewpromo']}}
{{$productOrderCtrl.translations['antibody.pdp.commerceCard.promotion.promocode']}}: {{promo.promoCode}} {{promo.promoTitle}} {{promo.promoDescription}}. {{$productOrderCtrl.translations['antibody.pdp.commerceCard.promotion.learnmore']}}
产品信息
TA501028
种属反应
宿主/亚型
分类
类型
克隆号
抗原
偶联物
形式
浓度
规格
纯化类型
保存液
内含物
保存条件
运输条件
靶标信息
The protein encoded by this gene is a member of the protein tyrosine phosphatase family. PTPs are known to be signaling molecules that regulate a variety of cellular processes including cell growth, differentiation, mitotic cycle, and oncogenic transformation. Two alternatively spliced transcript variants of this gene have been reported, one of which encodes a receptor-type PTP that possesses a short extracellular domain, a single transmembrane region, and two tandem intracytoplasmic catalytic domains; Another one encodes a PTP that contains a distinct hydrophilic N-terminus, and thus represents a nonreceptor-type isoform of this PTP. Studies of the similar gene in mice suggested the regulatory roles of this PTP in RAS related signal transduction pathways, cytokines induced SATA signaling, as well as the activation of voltage-gated K+ channels.
仅用于科研。不用于诊断过程。未经明确授权不得转售。
篇参考文献 (0)
生物信息学
蛋白别名: protein tyrosine phosphatase, receptor type, epsilon polypeptide; Protein-tyrosine phosphatase epsilon; PTP epsilon; PTPvarepsilon; Receptor-type tyrosine-protein phosphatase epsilon; unnamed protein product
基因别名: HPTPE; PTPE; PTPRE; R-PTP-EPSILON
UniProt ID: (Human) P23469
Entrez Gene ID: (Human) 5791